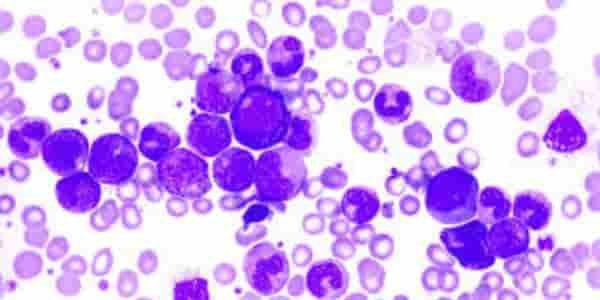

En Clínica Merinos contamos con un servicio especializado en el diagnóstico, tratamiento y seguimiento de enfermedades de la sangre y del sistema hematológico. Nuestro equipo de hematólogos brinda una atención integral, precisa y humana, enfocada en identificar alteraciones de manera temprana y ofrecer terapias adecuadas para cada paciente.
¿Por qué elegir nuestro servicio de Hematología?
Hematólogos especializados con amplia experiencia en el manejo de enfermedades benignas y malignas de la sangre.
Diagnóstico oportuno y preciso, apoyado en estudios de laboratorio avanzados.
Atención personalizada, orientada a comprender y resolver cada caso clínico.
Manejo integral y seguro de patologías crónicas o complejas.
Acompañamiento continuo durante el tratamiento y el seguimiento evolutivo.
Principales evaluaciones, tratamientos y patologías atendidas
Enfermedades de la Sangre
Anemias de diferentes orígenes.
Trastornos de coagulación y sangrado.
Trombosis y problemas de coagulación.
Alteraciones de plaquetas.

Enfermedades Hematológicas Crónicas
Leucemias.
Linfomas.
Mieloma múltiple.
Síndromes mielodisplásicos.
Trastornos Infecciosos y Autoinmunes
Infecciones relacionadas con alteraciones hematológicas.
Púrpura trombocitopénica inmunitaria (PTI).
Anemias hemolíticas autoinmunes.

Procedimientos y Evaluaciones Especializadas
Revisión completa de hemograma.
Aspirado y biopsia de médula ósea.
Pruebas de coagulación avanzadas.
Seguimiento de terapias específicas.

Beneficios de atenderte con nosotros
Diagnóstico temprano, clave para un tratamiento efectivo.
Manejo seguro y especializado de enfermedades complejas.
Tratamientos personalizados, basados en evidencia médica actual.
Mejora en la calidad de vida, mediante seguimiento continuo y adecuado control clínico.
Atención humana y confiable, brindada por especialistas comprometidos con tu bienestar.
